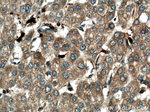
S100A9 Antibody in Immunohistochemistry (Paraffin) (IHC (P))

Search
Proteintech
S100A9 Polyclonal Antibody
{{$productOrderCtrl.translations['antibody.pdp.commerceCard.promotion.promotions']}}
{{$productOrderCtrl.translations['antibody.pdp.commerceCard.promotion.viewpromo']}}
{{$productOrderCtrl.translations['antibody.pdp.commerceCard.promotion.promocode']}}: {{promo.promoCode}} {{promo.promoTitle}} {{promo.promoDescription}}. {{$productOrderCtrl.translations['antibody.pdp.commerceCard.promotion.learnmore']}}
产品信息
26992-1-AP
种属反应
已发表种属
宿主/亚型
分类
类型
抗原
偶联物
形式
浓度
规格
纯化类型
保存液
内含物
保存条件
运输条件
产品详细信息
Immunogen sequence: KLGHPDTLN QGEFKELVRK DLQNFLKKEN KNEKVIEHIM EDLDTNADKQ LSFEEFIMLM ARLTWASHEK MHEGDEGPGH HHKPGLGEGT P (25-114 aa encoded by BC047681)
靶标信息
S100A9 (MRP-14) is a member of the S100 family of proteins containing 2 EF-hand calcium-binding motifs. S100 proteins are localized in the cytoplasm and/or nucleus of a wide range of cells, and involved in the regulation of a number of cellular processes such as cell cycle progression and differentiation. S100 genes include at least 13 members which are located as a cluster on chromosome 1q21. This protein may function in the inhibition of casein kinase and altered expression of this protein is associated with the disease cystic fibrosis.
仅用于科研。不用于诊断过程。未经明确授权不得转售。
生物信息学
蛋白别名: BM-009; calgranulin B; Calgranulin-B; Calprotectin L1H subunit; DKFZp686B04128; Leukocyte L1 complex heavy chain; Macrophage; Migration inhibitory factor-related protein 14; Monocyte; MRP-14; MRP15; MRP16; Protein S100-A9; S100 A9; S100 calcium-binding protein A9; S100A9; unnamed protein product
基因别名: 60B8AG; AW546964; BEE22; CAGB; CFAG; CGLB; GAGB; L1AG; LIAG; MAC387; MIF; MRP14; NIF; P14; S100-A9; S100A9
UniProt ID: (Human) P06702, (Mouse) P31725
Entrez Gene ID: (Human) 6280, (Mouse) 20202